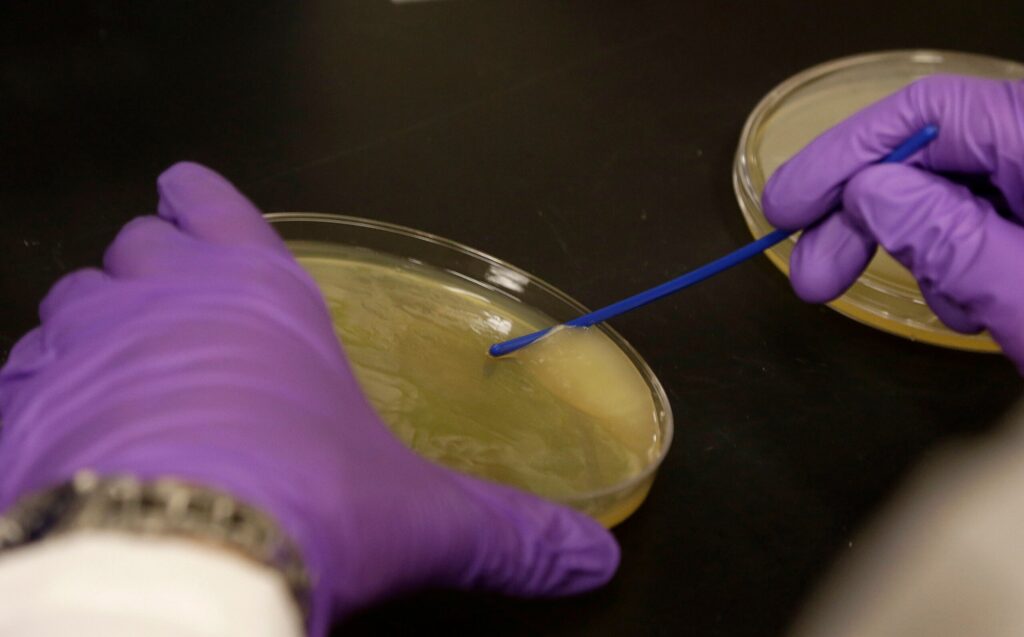
Blue-green algae

Invisible yet influential, bacteria inhabit our bodies, playing roles that extend beyond causing illness. These single-celled organisms might help enhance sleep quality or boost exercise motivation.
Timothy Paustian, a professor at the University of Wisconsin-Madison’s Department of Bacteriology, highlights our reliance on these microorganisms. “They’re really important for your health. You have a whole group of organisms that live inside you,” Paustian explained.
Appearing on WPR’s “The Larry Meiller Show,” Paustian delved into the vital world of bacteria.
These organisms consume proteins, fats, and carbohydrates similar to human diets. According to Paustian, some bacteria can even break down gasoline or produce hydrogen gas, while others grow from light like plants.
Bacteria vary in shape, color, and size. During summer, Wisconsin’s lakes often experience “blooms” of cyanobacteria, or blue-green algae, due to nitrogen and phosphorus runoff, warm temperatures, and calm waters. More on cyanobacteria can be found here.
Bacteria: Friend or Foe?
While bacteria are often associated with diseases like salmonella and tuberculosis, these harmful types represent less than 100 out of approximately 18,000 species. The key is maintaining balance with these microorganisms.
Paustian noted, “E. coli is normally a good friend of ours and lives in our colon, but if it picks up the wrong set of genes, it can cause terrible diarrhea.”

Effective hygiene practices, like washing hands with soap and hot water, can eliminate bacteria from the skin. Hand sanitizers also help reduce bacteria, and heating objects to 115 degrees Fahrenheit can kill most harmful bacteria.
Paustian cautioned against the notion of eradicating all bacteria. “Bacteria are your friends,” he emphasized. “I want to keep emphasizing that, and you really don’t want to get rid of them a lot of the time.”
Gut Microbes: Influencing Sleep and Mental Health
Research suggests bacteria can enhance life quality. The gut microbiome, comprising bacteria in our intestines, aids nutrient digestion.
“Your microbiome might be influencing your sleep, and this can have real world consequences,” Paustian shared. “For example, shift workers are more likely to develop obesity and diabetes, and (researchers) think that might have a relation to their microbiome.”
Paustian referenced a study where lactobacillus gasseri improved sleep quality in stressed medical students.
The gut microbiome’s connection to mental health is under investigation. Studies have shown that when the microbiome from a depressed individual is transplanted into mice, the mice exhibited anxiety and depression. Additionally, bacteria groups like Eubacterium and Coprococcus may boost exercise motivation.
While probiotics are marketed for gut health, Paustian expressed curiosity about their persistence in the body. “If you take a probiotic, it will survive your stomach, but it doesn’t take up residence in your microbiome. You have to keep taking it,” he explained.
Paustian advises conducting personal research, particularly seeking out double-blind studies that confirm a probiotic’s efficacy.